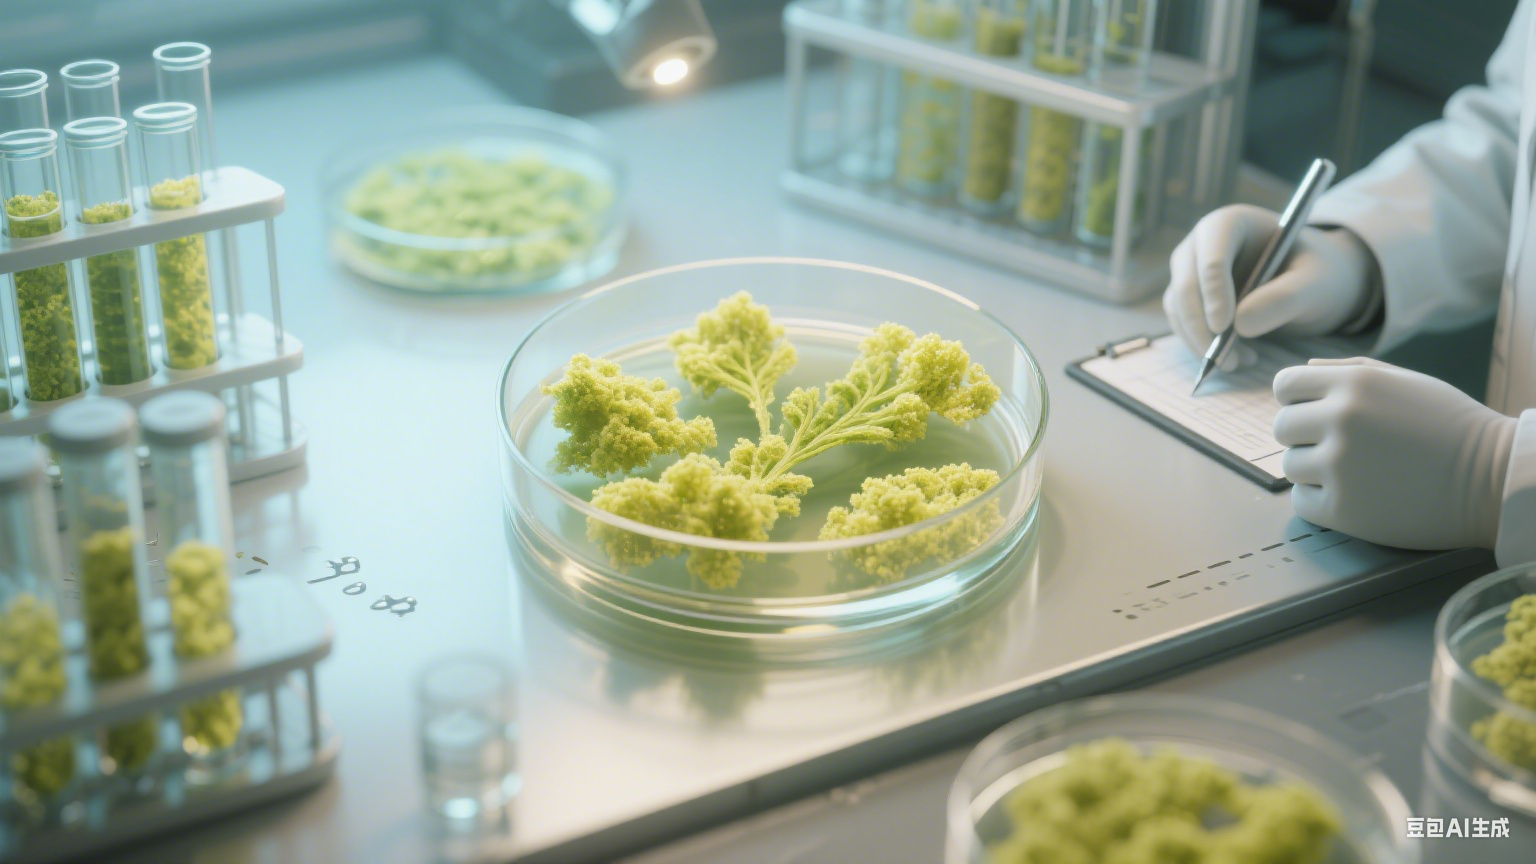
细胞织就的星河：生命密码里的诗意重构

当阳光透过显微镜的镜片,落在载玻片上那片透明的生命疆域,无数个椭圆的细胞便成了宇宙中最微小的星辰。它们裹着淡蓝的细胞膜,将遗传密码妥帖收藏在细胞核的褶皱里,像古老羊皮卷上的神秘图腾,在时光长河里静默流转。细胞工程,这场以科学为针、以技术为线的创作,正用人类的智慧轻轻挑动这些生命星辰的轨迹,让原本孤立的细胞群落,织就出跨越物种的璀璨星河。
从第一株试管里绽放的烟草愈伤组织开始,细胞工程便带着诗意的勇气叩击生命的大门。那些原本在植株体内各司其职的细胞,被科研者从母体中温柔剥离,在无菌的培养皿中获得新生。它们不再受限于根茎叶的束缚,像挣脱了地心引力的种子,在营养基的滋养下肆意生长,最终聚成一团团嫩黄的生命聚落。这不是对自然的征服,而是一场温柔的对话 —— 人类以谦卑的姿态倾听细胞的低语,再用技术的韵律引导它们踏上新的旅程。
在植物细胞的世界里,细胞工程是最细腻的园艺师。它能让一粒水稻细胞在实验室里长出完整的植株,稻穗上还结着饱满的谷粒,每一颗都镌刻着抗病的基因密码;也能让番茄与马铃薯的细胞跨越物种的界限,在培养皿中相拥融合,最终长出既结番茄又长土豆的神奇植株,仿佛在大地上谱写一曲跨界的生命恋歌。这些并非童话中的幻想,而是细胞工程用科学的笔触,在自然的画卷上添上的浪漫一笔。
动物细胞工程则更像一位温柔的生命守护者,在微观世界里守护着人类的健康。当患有糖尿病的患者需要胰岛素时,科研者会将人类胰岛素基因导入大肠杆菌的细胞中,让这些微小的生命成为 “微型药厂”,日夜不停地生产出拯救生命的药物;当烧伤患者的皮肤难以愈合时,皮肤干细胞会在实验室的培养瓶中慢慢生长,最终形成一片完整的皮肤组织,像一片小小的绿洲,为患者带来重生的希望。这些场景里没有冰冷的仪器,只有细胞与人类之间的深情羁绊,每一个细胞都在为生命的延续而努力跳动。
细胞融合技术更是将这种诗意推向了极致。当小鼠的 B 淋巴细胞与骨髓瘤细胞在电融合仪的作用下轻轻相拥,它们便融合成了杂交瘤细胞,这些细胞既能像 B 淋巴细胞一样产生特异性抗体,又能像骨髓瘤细胞一样无限增殖。每一个杂交瘤细胞都像一位忠诚的卫士,不断分泌出对抗疾病的抗体,为人类抵御乙肝、狂犬病等疾病的侵袭。这就像两个不同的生命个体,跨越了种族与形态的差异,最终携手并肩,为守护更广阔的生命世界而奋斗。
胚胎工程则在生命的起点处书写着浪漫。当牛的受精卵在体外培养皿中慢慢分裂,从一个细胞变成两个、四个、八个…… 最终形成早期胚胎,再被移植到母牛的子宫中,它们便会在那里继续生长发育,最终诞生出健康的小牛犊。这些小牛犊身上或许携带着来自世界各地的优良基因,有的能产更多的牛奶,有的能抵抗更恶劣的环境。这就像一场跨越时空的生命接力,科研者用细胞工程的技术,将优秀的生命基因传递下去,让每一个新生命都能在更好的起点上开始自己的旅程。
在细胞工程的世界里,每一个细胞都是有温度的生命个体,每一次实验都是与自然的温柔对话。我们不是在改造自然,而是在理解自然的基础上,与细胞一起探索生命的更多可能。当我们在显微镜下看到细胞缓慢分裂、生长、融合时,看到的不仅仅是科学的奇迹,更是生命本身的坚韧与浪漫。那些在培养皿中生长的细胞,那些为人类健康而努力的细胞,都在以自己的方式,诉说着生命的美好与力量。
或许有一天,当我们漫步在田野间,看到结满果实的跨界植株;当我们在医院里,看到患者因细胞工程药物而重获健康;当我们在实验室里,看到新的生命在胚胎培养皿中悄然萌芽,我们会想起,这一切都源于人类对细胞的温柔探索。细胞工程就像一束光,照亮了微观世界的生命星河,也照亮了人类与自然和谐共处的未来之路。而这条路上,还有更多的细胞在等待我们去倾听,还有更多的生命故事在等待我们去书写。
免责声明:文章内容来自互联网,本站仅提供信息存储空间服务,真实性请自行鉴别,本站不承担任何责任,如有侵权等情况,请与本站联系删除。